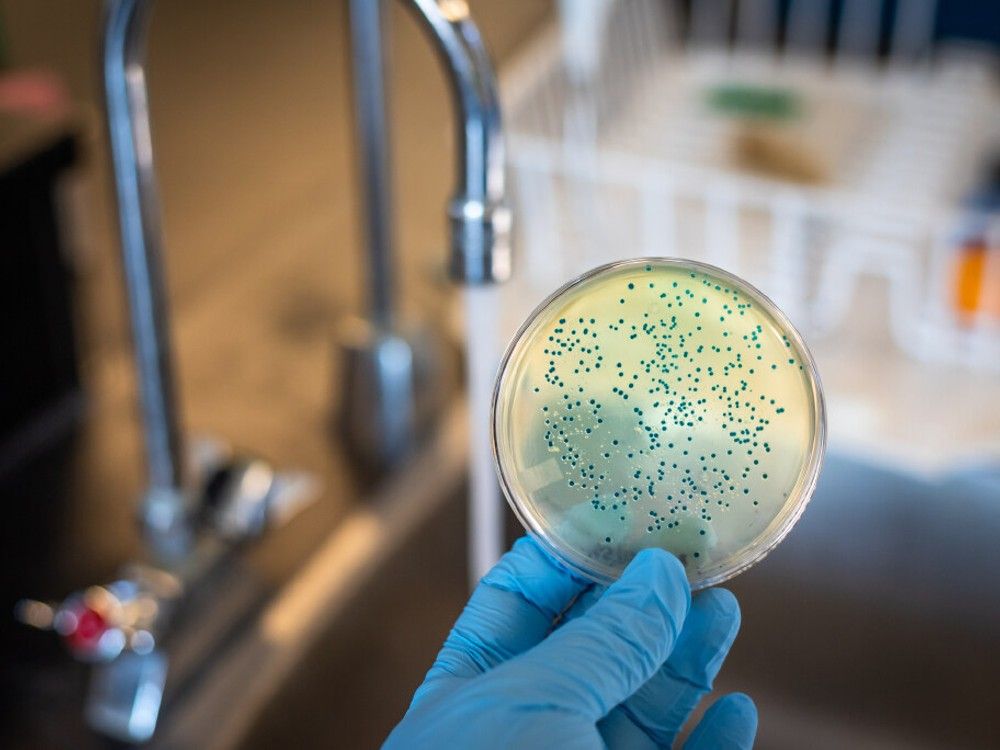
Illustration shows E.coli bacterial cultures in petri dishes

Breadcrumb Trail Links
News Local News
The provincial health authority has not, as yet, detailed how the outbreak began and what’s behind it

Article content
An E. coli outbreak connected to multiple daycares and other institutions in Calgary has left dozens of children seeking treatment at the city’s emergency departments.
As many as 50 children sought care in hospitals, Alberta Health Services said in a statement issued late Monday. The health authority has declared an outbreak for five daycares and six other institutions, all linked to 17 lab-confirmed cases.
Advertisement 2
Article content
Article content
“Families with children attending any of the above locations are being sent letters advising of the outbreak and are being asked to monitor for symptoms and present to an emergency department if necessary,” Alberta Health Services said in its statement.
Here’s what to know about the infectious disease and how to look out for it.
What is E. coli?
Escherichia coli, its full name, is a type of bacteria commonly found in the intestines of animals and humans. There are hundreds of strains of the bacterium, most of which are harmless or may cause brief diarrhea.
A few strains, such as E. coli O157:H7 — which commonly behind outbreaks in Canada and U.S. — have been identified as dangerous to people and can cause severe stomach cramps, vomiting and bloody diarrhea.
How does it spread?
It is usually found in meat, but can also spread through unpasteurized milk, sandwich meats, raw vegetables, cheese and contaminated water. Produce grown close to the ground can also be susceptible to contamination from the bacterium if, for instance, it comes in contact with runoff from cattle farms.
Article content
Advertisement 3
Article content
Once someone has eaten contaminated food, the infection can spread from person to person by hand-to-mouth contact. It can also transmit from animals to people.
The provincial health authority has not yet detailed how the outbreak began and what’s behind it.
What do symptoms look like?
Generally symptoms appear within three to four days of ingesting the contaminated food but can also appear anywhere from within hours to up to 10 days.
Someone infected with the bacterium may experience severe abdominal cramping, bloody or non-bloody diarrhea, reduced appetite, nausea and fatigue.
How do I know if my symptoms are serious?
Most symptoms end within five to 10 days. But if your symptoms persist or if you see blood in urine or diarrhea, call your doctor.
Who is most at risk?
Pregnant women, young children and older adults are more likely than others to develop serious complications from the infections.
Do I need treatment if I am infected?
Most people with an E. coli infection recover on their own in days. There is no official treatment for the infection and it is generally recommended to not use antibiotics, as the bacterium releases a toxin into the cell and if the cell is killed with antibiotics, the toxin can pass into the bloodstream.
Advertisement 4
Article content
In some cases, the infection can lead to a serious illness requiring urgent care or long-term complications. According to CBC, the contamination can, in a small number of cases, lead to hemolytic uremic syndrome (HUS), a life-threatening condition that kills three to five percent of those afflicted and requires treatment in hospital intensive care units.
It is however, rare for an infection to be fatal. Sometimes a person can be infected without any symptoms and unknowingly pass it on to others.
How do I avoid catching E.Coli?
Since the bacterium usually passes from person to person, practicing good hygiene habits can go a long way in preventing infection. Wash your hands thoroughly and frequently, wash fruits and vegetables before cooking or preparing them, sanitize all utensils before usage and avoid contact with anyone confirmed to be sick.







Comments
Postmedia is committed to maintaining a lively but civil forum for discussion and encourage all readers to share their views on our articles. Comments may take up to an hour for moderation before appearing on the site. We ask you to keep your comments relevant and respectful. We have enabled email notifications—you will now receive an email if you receive a reply to your comment, there is an update to a comment thread you follow or if a user you follow comments. Visit our Community Guidelines for more information and details on how to adjust your email settings.
Join the Conversation